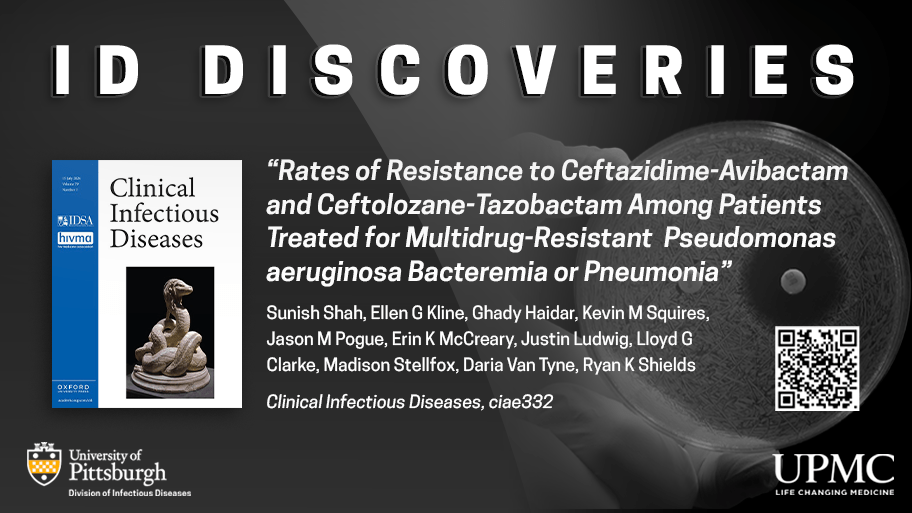

Category: Publications
DISCLAIMER: The information contained does not reflect the views of the University of Pittsburgh School of Medicine. The content of this blog should not be used as a reference for specific treatment recommendations regarding patients.